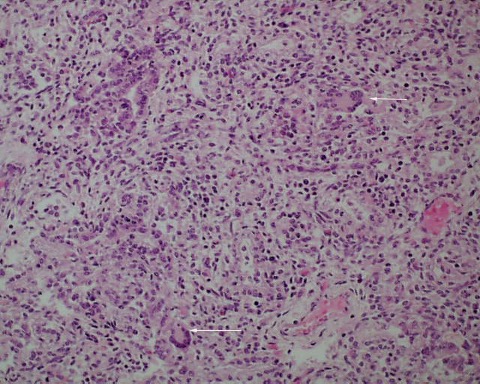
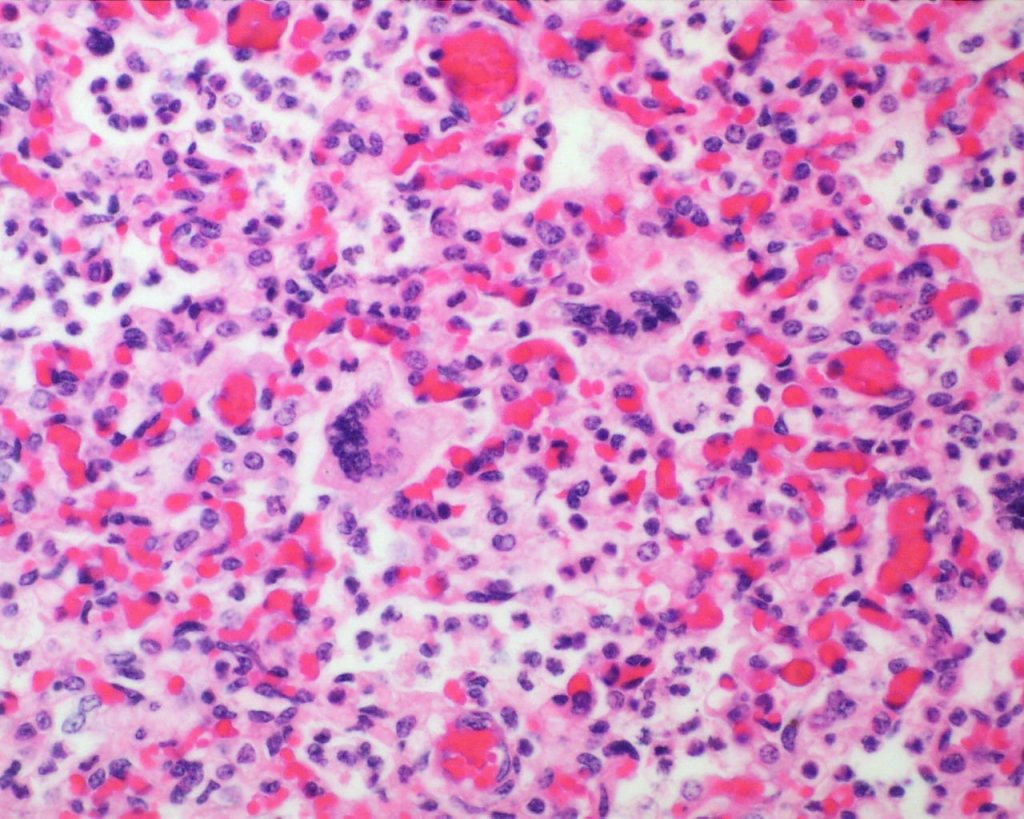

The majority of studies of the immature lung are related to neonatal concerns. However, the lung also provides important information about fetal events unrelated to its respiratory role after birth.
Microbiologic culture:
After the skin incisions, but before handling the lung, is the opportune time to obtain microbiologic cultures from it as the external surfaces can be kept sterile. The prosector can carefully cut through the cartilaginous chest cage on the left side and then lift the plate to the right to cut and remove it, being careful not to contaminate the right chest with instruments. Then with a sterile forceps and scissors, often available as a suture removal kit, the lower right lobe can be lifted up and a small piece cut free. The lung is a useful microbiologic sample of amniotic fluid that was in continuity with lung fluid. Experience has shown that without chorioamnionitis, the culture is negative. With fetal infection, the culture will grow aerobic and anaerobic pathogens, and with special media, Neisseria gonorrhoeae. Some common organisms such as Ureaplasma would need special media to grow, but these microorganisms are not directly responsible for fetal death. The lung sample could also be used for PCR or genomic methods to detect microorganisms.
Gross examination:
Color: The normal lung is pink. In the stillborn infant, it may be red from hemoglobin staining from autolysis or from vascular congestion, or rarely pneumonitis. Petechiae of the visceral pleura may be present. The significance of the petechiae is discussed in the section on thymus. If the fetus is anemic, the lungs will be paler than normal. With bacterial overgrowth there may be visible foci of gaseous expansion on the surface. Foci of pneumonitis or deep hemorrhage may be seen on the surface.
Pulmonary hypoplasia: Pulmonary hypoplasia may be apparent on opening the chest because the small lungs are obscured by the heart (Fig 1a,b).


The lung lobules should be identified noting three on the right and two lobes with a lingua on the left (Fig 2).

After opening the bronchi and pulmonary arteries, the lungs can be cut off at the hilum and weighed separately. The combined lung weights can be evaluated by the lung to brain weight ratio, but pulmonary hypoplasia is defined by the lung to body weight ratio. Above 28 weeks of gestation the lung: body weight ratio below 0.012 ratio is evidence of pulmonary hypoplasia1. Below the gestation the cut off is 0.015.
Pulmonary hypoplasia is usually a secondary effect of one of two very different mechanisms. The first mechanism is severe oligohydramnios/ anhydramnios that causes a loss of the intrauterine pressure transmitted from the amniotic fluid to the lung that normally causes an outward expanding pressure in the airways. The underlying cause of the oligohydramnios is not a direct factor on the pulmonary hypoplasia. Indirectly, the acuteness of onset and the degree of loss of intrapulmonary pressure are modulating factors. Oligohydramnios can vary from complete and constant in absent fetal kidneys to sudden onset with premature rupture of membranes. The causes of oligohydramnios will be discussed in a chapter on fetal anomalies associated with perinatal death.
The proof that that intra-airway-pressure controlled lung volume was circuitous. Multiple clinical reports confirmed that normal lung volume occurs in monoamniotic twins in which one twin has an anomaly that should have produced lethal oligohydramnios2. The anuric twins had urinary obstruction from VATER association and caudal dysgenesis. The clinical observation does not distinguish between the lung growth due to amniotic fluid pressure or due to a renal secretion into the amniotic fluid.
An experimental study in lambs demonstrated that chronic externalized drainage of fetal pulmonary secretions results in pulmonary hypoplasia3. The experiment reduced airway pressure, but this was not definitive proof the lower pressure caused the hypoplasia because a urine growth factor would not have entered the lung. Experimental tracheal ligation did prove the converse, that blocking egress of lung secretions increased airway pressure and resulted in enlarged lungs, a finding also evident in human tracheal and laryngeal atresia4-7. An in-vitro study demonstrated that stretch stimulated rat lung epithelial cell proliferation. Creating drainage of the amniotic fluid into the maternal peritoneal cavity was a common experimental model of producing oligohydramnios and pulmonary hypoplasia8,9. In this model in the lamb, pressu tracheal pressure rose above amniotic pressure, decreasing lung fluid volume10 (2). Intra-amniotic pressure measurements in humans with oligohydramnios also demonstrated decreased pressure. Direct experimental demonstration of the role of amniotic pressure in lung growth was achieved by producing pulmonary hypoplasia in rabbits by cutting an aperture in the uterine wall that reduced measured amniotic pressure11. In this model, any urine growth factors would still have been ingested. Nicolini et.al. refined the hypothesis by noting that lung fluid egress during respiration would be less than lung fluid production at normal amnion pressures, but exceed production at the amniotic pressure found with oligohydramnios 12. The complete hypothesis is that the trachea to amnion pressure gradient controls lung growth via the flow of fluid with the likely consequence that decreased lung fluid volume decreases distal airway stretch. Such a mechanism would adjust pulmonary growth to fit the pleural cavity, for example mass lesions or a constricting thorax would produce a counteracting increased intrathoracic pressure to constrain airway growth.
The role of a brief decrease in amnion pressure from amniocentesis on lung growth was more difficult to ascertain. Because of a clinical assessment of increased respiratory distress in infants who had undergone amniocentesis, a small study was done in monkeys demonstrating pulmonary hypoplasia with early gestation, but not late gestation amniocentesis13. The decreased lung volume was not quantified in the report, and the affected monkey infants also had a lower birth weight. Another study measured crying capacity in infants with and without amniocentesis and found a decreased volume in the amniocentesis group14. Both studies had only small numbers of subjects and small effects.
The other mechanism producing pulmonary hypoplasia is a mirror image of oligohydramnios in that external forces within the chest cause restricted lung growth by opposing the lung expansion from the amniotic fluid pressure. These forces may include an intrathoracic mass effect from tumor or fluid (Fig 3a, b)


, or restriction of the thoracic volume by an osteochondrodystrophy (Fig 4a, b).


A diaphragmatic hernia is another form of mass effect, but in addition may also have a primary abnormality of lung development on the side with the hernia. Even in the normal thorax, the smaller left, compared to right, lung may be smaller because of the predominance of the heart mass in the left side of the thoracic cavity. Fluid having a mass effect is usually from a pleural effusion from anasarca due to heart failure which is termed by tradition as fetal hydrops. The causes of fetal hydrops will be presented in the obstetrical pathology chapter on fetal anomalies associated with perinatal death. A less common cause of pleural effusion is an abnormality of lymphatic drainage either from thoracic lymphangiectasia and failure of normal thoracic duct formation. Lymphatic fluid has a higher protein content than that in an effusion. An abnormality of lymphatic drainage may be associated with a mediastinal shift from asymmetric fluid accumulation (Fig 5a, b).


The lungs were not technically hypoplastic with a lung: body weight ratio of 0.02, but the amount of air way tissue was decreased.
The duration of the underlying cause of pulmonary hypoplasia can, in certain circumstances, be estimated from the gestation that corresponds to the weight of the lung. For example, in pulmonary hypoplasia following premature rupture of membranes at 22 weeks of gestation and delivery at 26 weeks of gestation, the weight of the lung is usually close to the lung weight expected for 22 weeks of gestation. Similarly, in heart failure due to acute partial asphyxia and rapid progression to fetal death, the lung weight should be normal for gestation despite the presence of pleural effusions. This relationship does not hold for more chronic causes of lung hypoplasia.
Pulmonary hyperplasia: The complete obstruction of the larynx or trachea paradoxically increases intrapulmonary pressure by occluding the egress of pulmonary secretions from the lung. This elevated pressure stimulates increased, although morphologically distorted, lung growth, and hence heavy lungs (Fig 6 a, b).


Bronchi: After removing the organ block from the chest cavity, the larynx and trachea are opened posteriorly to access patency and normal cartilage formation, and normal proximal branching. There may be aspirated meconium, vernix or blood in the lumen.
Microscopic examination:
Sampling: One system of taking samples for microscopy that facilitates both identifying the lobes on the slide and obtaining two perspectives of a branching system of bronchioles, is to slice the lung perpendicular to the main bronchus in the upper lobe, and parallel in the lower lobes. The cut sections of the lung may reveal aspirated material, or may demonstrate focal lesions usually hemorrhagic areas that can be sampled (Fig 7). Occasionally, usually in infants with oligohydramnios, there may be a pale focus from a congenital cystic adenomatoid malformation.

Postmortem retention: The bronchial epithelial cells demonstrate loss of nuclear basophilia at more than 96 hours of postmortem retention. The tracheal cartilage loses nuclear basophilia after 1 week of postmortem retention. Loss of basophilia is defined as at least 1% of nuclei are entirely devoid of basophilic staining15. (Fig 8)

Lung development: The lungs progressively branch and then begin maturation during intrauterine development (Fig 19a, 9a-c) Lung development proceeds in orderly overlapping phases throughout gestation. These phases have classically been divided into: 1) embryonic (26 days to 6 weeks); 2) pseudoglandular (6 to 16 weeks); 3) acinar or canalicular (16 to 28 weeks); 4) saccular (28 to 34 weeks); and 5) alveolar (34 weeks to term and up until 2 years of age)16.




Descriptively, there is a regular progression of microscopic features. During the canalicular period, capillaries begin to approach the airway epithelium, beginning a progressive development of the terminal sacs with progressive thinning of the airway epithelium and protrusion of capillaries covered by thin Type 1 alveolar cells into the airspace. This progression increases the area of gas exchange. Bronchiolar type 2 cells are also maturing to produce surfactant. Multiple morphometric measures of the lung, such as volume proportion of air spaces, have good correlation with gestational age 17A simple quantitative method to estimate gestation from the lung is the radial alveolar count which is exponentially related to gestation after 18 weeks 18
Pleura: As with other intrathoracic organs, the pleural surface can confirm the petechial hemorrhages seen grossly (Fig 10).

Aspirated material in the airways: In utero, there are shallow respiratory movements approximating the volume of the trachea. With acute asphyxia, the stimulation of fetal gasping may draw more material into the lung. The nature of the material aspirated depends on the maturation of vernix and the presence as well as the dilution of “foreign” material such as blood, microorganisms, neutrophils, or meconium (fetal colonic content) in the amniotic fluid. Viscous material such as meconium or mature vernix may plug and even distend bronchi. The viscosity of aspirated meconium depends on the ratio of amniotic fluid to meconium before being aspirated. Aspirated material initially confined to the bronchi could disperse overtime particularly in a living fetus with a continued respiratory effort.
Infection: Even without gasping, microorganisms and neutrophils present in infected amniotic fluid would be able to traverse into the airways from normal, shallow respiration. This is also likely true for mobile neutrophils in the amniotic fluid. In previable fetuses, cuboidal cells lining the airways shed into the lumen and undergo karyorrhexis (apoptosis) that may resemble, but are morphologically distinct from neutrophils (fig 11a,b).

However, the karyorhectic cells lack the intact cytoplasm of neutrophils. It is not possible to observationally determine whether neutrophils in the airway are from aspiration of neutrophils in the amniotic fluid, or are from fetal neutrophils in response to aspirated bacteria. The exception is with focal bronchopneumonia which demonstrates a fetal inflammatory response with large, focal accumulations of neutrophils and vasodilatation of surrounding capillaries (fig 12a,b).


It is conceivable that bacteria can travel through the fetal airways after fetal death, but neutrophils in the lungs and gastrointestinal tract are presumed evidence of chorioamnionitis in the living fetus. Overgrowth of bacteria may be directly observable in the airways. Some organisms in stillbirth without postmortem retention, such as Group B beta hemolytic streptococcus show such overgrowth in the living fetus, while in other cases the bacterial overgrowth is likely postmortem (even if initially present in life), especially for organisms adapted to low environmental oxygen (Fig 13).

Giant cell pneumonitis and interstitial pneumonitis can also be seen in stillbirth, but these features do not indicate a specific etiology19. Fungal, viral and protozoic should be excluded (Fig 14a-c).

Meconium/Vernix: Meconium can be identified by pigmented protein globules mixed with vernix (Fig 15 a-c).



Vernix can be identified by amorphous material mixed with lanugo hair and numerous squames (the shed cells of the stratum corneum). Squames may be present in meconium from fetal swallowing or from mixing with vernix after expulsion. Meconium is more likely to be passed at later gestational age and can be passed in response to asphyxia. Ultrasound studies and green second trimester fluid at amniocentesis has complicated our understanding of meconium passage. The duration of meconium presence in the amniotic fluid can be dated for short intervals by macrophages in the fetal membranes.The significance of meconium is discussed in the chapter on meconium. In the lung meconium macrophages are very rare in stillbirth. Either fetal death always occurs before a response can be elicited or more likely meconium is tolerated within the lung. There are reports of meconium eliciting inflammation in the lung, but this is not usual if there is no evidence of chorioamnionitis20. With chorioamnionitis with neutrophils and meconium are frequently mixed in the lung (Fig 16).

If the meconium or vernix is occluding deep airways, the inference is that it was transported into the lung by gasping. If there are only scattered squames in a late third trimester lung, then the possibility of simple mixing during normal fetal respiration cannot be excluded (17a, b).


In younger gestation fetuses with large volumes of amniotic fluid and little maturation of stratum corneum, even gasping would be unlikely to demonstrate large numbers of squames in the airways. I am unaware of a quantitative study of numbers of squames in the airway compared to gestation and intrathoracic petechiae as an independent indicator of gasping.
Blood: Blood can be aspirated from two sources. One is fetal hemorrhage into the amniotic fluid. Fetal hemorrhage is usually confined within the fetal external barriers, such as skin, amnion or umbilical cord surface. However, on occasion, from a ruptured chorionic vessel the amnion may be breached (Fig 18).

Such hemorrhage into the amnion fluid may also be iatrogenic from needle punctures or rupture of membranes. The other source is maternal blood. This may be from rupture of a subchorionic thrombohematoma, or hematoma in the decidua beneath the membranes, or even maternal blood aspirated during the delivery (19a-d).




Blood from old hematomas is degenerated with loss of cell outlines, but ingested fresh blood will have normal red cell morphology. Retroplacental hematomas, including those producing clinical placental abruption, do not have access to the fetal compartment unless the blood extends beneath the margin, and the fetal membranes have ruptured. Blood in the airways will eventually be phagocytized with resulting hemosiderin residing in alveolar macrophages that could be detected in respiratory secretions. In living neonates, it is not clear that the blood is harmful, but if gasped in sufficient quantity could appear as an infiltrate on chest radiograph.
Hemorrhage and congestion:
Beside hemorrhage in the visceral pleura, there may be deeper connective tissue interstitial hemorrhage in the lung. The capillaries in other areas of the lung with pleural petechiae are often engorged as well, and the rigors of gasping and pressure change may account for deeper hemorrhages (Fig 20a, b).


Focal hemorrhages may also be found in the airways usually with evidence of hemorrhages in other organs suggestive of disseminated intravascular coagulation and shock (Fig 21).

The mechanism for many hemorrhages is obscure. With elevated left atrial pressure, for example with heart failure, but more acutely with closure of the ductus arteriosus, elevated atrial pressure would be reflected in dilatation of the pulmonary veins in the septa (Fig 22).

In turn this pressure should passively increase pulmonary capillary pressure. A similar increase in atrial pressure occurs with sudden acute twin transfusion prior to death (Fig 23).

In severely autolytic lung, the distinction between intrinsic hemorrhage and aspirated blood may not be discernable with only iron staining for hemosiderin to trace the vestige of the hemorrhage (Fig 24).

Distal airway expansion: The lung in the fetus is naturally in the unexpanded state. With respiratory effort, even in fluid, there may be some expansion of the air passage. A complicating postmortem event is focal expansion of airways with gas (Fig 25).


This gas is presumed to be from bacterial action in the lung, usually with no evidence of inflammation. The importance of this phenomenon is that it not be mistaken for postnatal respiration in a stillborn fetus not born in the hospital with the forensic inference that respiration had occurred and death was after delivery.
Pulmonary hypoplasia microscopic: With standard sections of the lung, pulmonary hypoplasia may demonstrate smaller lobules and a sheared appearance of the parenchyma compared to similarly sectioned gestationally matched controls (Fig 26). Radial alveolar counts can quantify that appearance by counting the septa crossed by a straight line from the most distal bronchiole to the pleural surface and comparing to expected numbers at gestation18.
References:
1. Wigglesworth JS. Perinatal Pathology. Philadelphia: W. B. Saunders Company; 1984.
2. McNamara MF, McCurdy CM, Reed KL, Philipps AF, Seeds JW. The relation between pulmonary hypoplasia and amniotic fluid volume: lessons learned from discordant urinary tract anomalies in monoamniotic twins. Obstet Gynecol 1995;85:867-9.
3. Alcorn D, Adamson TM, Lambert TF, Maloney JE, Ritchie BB, Robinson PM. Morphological effects of chronic tracheal ligation and drainage in the fetal lamb lung. J Anat 1977;123:649-60.
4. Wigglesworth JS, Desai R, Hislop AA. Fetal lung growth in congenital laryngeal atresia. Pediatr Pathol 1987;7:515-25.
5. Wright JR, Jr., Thompson DL, McBride JA, Liston RM. Asynchronous pulmonary hyperplasia associated with tracheal atresia: pathologic and prenatal sonographic findings. Pediatr Pathol Lab Med 1995;15:81-97.
6. King JC, Mitzner W, Butterfield AB, Queenan JT. Effect of induced oligohydramnios on fetal lung development. Am J Obstet Gynecol 1986;154:823-30.
7. Liu M, Xu J, Tanswell AK, Post M. Stretch-induced growth-promoting activities stimulate fetal rat lung epithelial cell proliferation. Exp Lung Res 1993;19:505-17.
8. Nakayama DK, Glick PL, Harrison MR, Villa RL, Noall R. Experimental pulmonary hypoplasia due to oligohydramnios and its reversal by relieving thoracic compression. J Pediatr Surg 1983;18:347-53.
9. Symchych PS, Winchester P. Potter’s Syndrome. Am J Pathol 1978;90:779-82.
10. Harding R, Hooper SB, Dickson KA. A mechanism leading to reduced lung expansion and lung hypoplasia in fetal sheep during oligohydramnios. Am J Obstet Gynecol 1990;163:1904-13.
11. Kizilcan F, Tanyel C, Çakar N, Büyükpamukçu N, A H. The effect of low amniotic pressure without oligohydramnios on fetal lung development in a rabbit model. Am J Obstet Gynecol 1995;173:36-41.
12. Nicolini U, Fisk NM, Rodeck CH, Talbert DG, Wigglesworth JS. Low amniotic pressure in oligohydramnios–is this the cause of pulmonary hypoplasia? Am J Obstet Gynecol 1989;161:1098-101.
13. Hislop A, Fairweather DV. Amniocentesis and lung growth: an animal experiment with clinical implications. Lancet 1982;2:1271-2.
14. Vyas H, Milner A, Hopkin I. Amniocentesis and fetal lung development. 1982;627-8.
15. Genest DR, Williams MA, Greene MF. Estimating the time of death in stillborn fetuses: I. Histologic evaluation of fetal organs; an autopsy study of 150 stillborns. Obstet Gynecol 1992;80:575-84.
16. Schittny JC. Development of the lung. Cell Tissue Res 2017;367:427-44.
17. Langston C, Thurlbeck WM. Lung growth and development in late gestation and early post natal life. Persp Pediatr Pathol 1982;7:203-35.
18. Cooney T, Thurlbeck W. The radial alveolar count method of Emery and Mithral: a reappraisal 2- Intrauterine and early postnatal growth. Thorax 1982;37:580-3.
19. Sgrignoli AR, Yen DR, Hutchins GM. Giant cell and lymphocytic interstitial pneumonia associated with fetal pneumonia. Pediatr Pathol 1994;14:955-65.
20. Burgess AM, Hutchins GM. Inflammation of the lungs, umbilical cord and placenta associated with meconium passage in utero. Review of 123 autopsied cases. Pathol Res Pract 1996;192:1121-8.